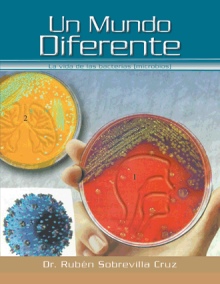

CUENTOS DE UN SOÑADOR
by
Other Books By Author
Book Details
Language :
Spanish
Publication Date :
3/28/2013
Format :
E-Book
Dimensions :
N/A
Page Count :
50
ISBN :
9781463354572
About the Book
Cuentos de un Soñador es una serie de cuentos donde el autor imagina situaciones cercanas a la realidad; para hacer meditar al niño de los grandes problemas de la vida. Con un fin del mundo que pudiera pasar si seguimos alterando el medio ambiente ocasionando un cambio climático que cambiara las condiciones de la vida: como las sequías que se observan producto de las alteraciones propiciadas por nosotros los hombres, la imaginación de los niños nos hacen pensar en las cosas hermosas que pueden suceder hasta lograr un diálogo con el Ser Supremo: el trato que debemos dar a los animales y a las plantas para mejorar la situación y cambiar nuestras actitudes.